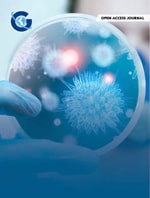
Hydroxychloroquine Pre-Exposure Prophylaxis to Prevent SARS-CoV-2 Among Health Care Workers at High Risk For SARS-CoV-2 Exposure: A Nonrandomized Controlled Trial

Infectious Diseases Diagnosis & Treatment
ISSN: 2577-1515
Impact Factor: 3.02
research article

Inhibition of Human Coronaviruses by Piperidine-4-Carboxamides
Xin Guo, Ayan Kumar Ghosh, Halli Miller, Konstance Knox, Madhuchhanda Kundu, Francis Peterson, David J Meyers, Ravit Arav-Boger,
Infectious Diseases Diagnosis & Treatmentresearch article
Hydroxychloroquine Pre-Exposure Prophylaxis to Prevent SARS-CoV-2 Among Health Care Workers at High Risk For SARS-CoV-2 Exposure: A Nonrandomized Controlled Trial
Vanessa N. Raabe, Andrew Fleming, Marie I. Samanovic, Lilin Lai, Hayley M. Belli, Mark J. Mulligan, H. Michael Belmont
Infectious Diseases Diagnosis & Treatmentresearch article

Co-Infections with Prioritary Pathogens in Patients with Severe Covid-19: What is the Factor Leading to the Death of the Patients?
Rosaria Cortese, Raffaele Squeri, Rosanna Intelisano, Smeralda D’Amato, Federica Denaro, Ioselita Giunta, Giuseppe Pantò, Anthony Privitera, Roberto Venuto, Carmelo Biondo, Giuseppe Mancuso, Vincenza La Fauci, Cristina Genovese,
Infectious Diseases Diagnosis & Treatmentcase report

First Case of Genetically Confirmed Travel Related COVID- 19 Re Infection in Oman
Fakhria Ali Hamed Al- Rashdi, Samira H. Al Mahruqi, ALGhalia Nasser ALYaqobi, Azza Al-Rashdi, Intisar ALShukri, Mezon Tufil
Infectious Diseases Diagnosis & Treatment

